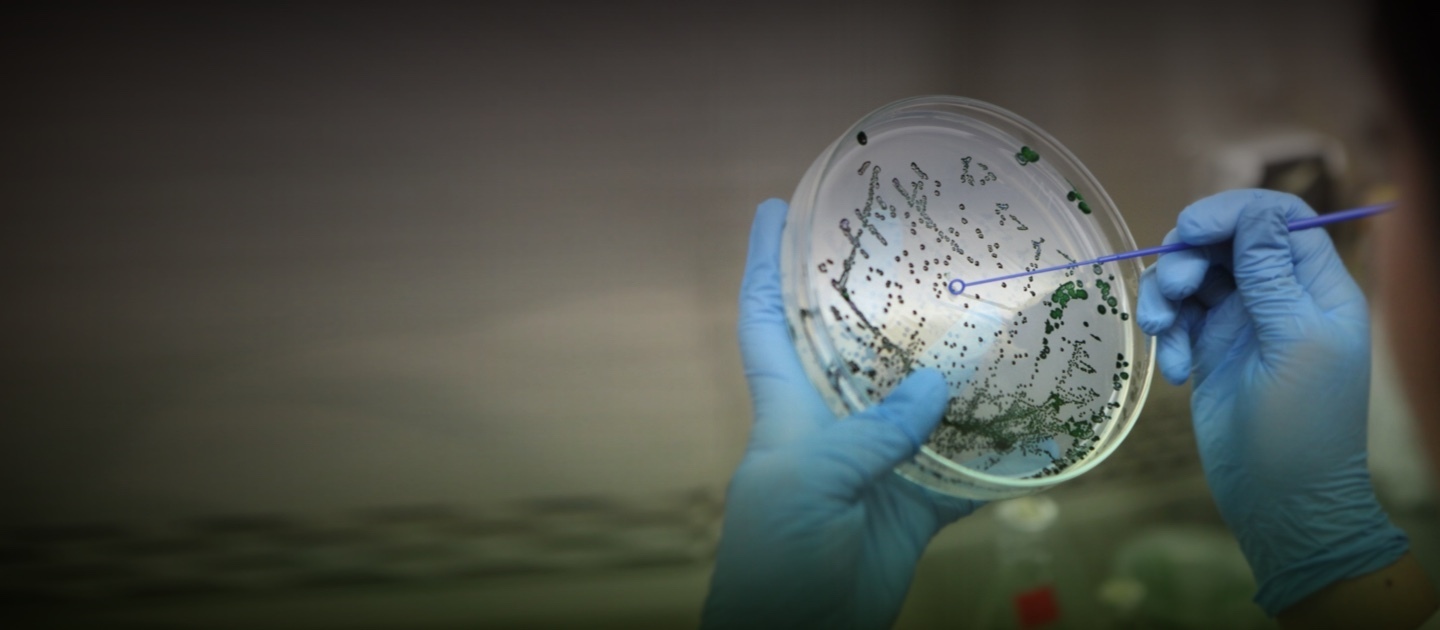

UC obtiene excelentes resultados en concursos de investigación Núcleos Milenio y Anillos
“Estamos muy contentos”, afirma el vicerrector de Investigación Pedro Bouchon, y con razón. La Universidad Católica obtuvo el más alto número de propuestas adjudicadas en las convocatorias 2021 de los Núcleos en Ciencias Naturales y Exactas, participando en cuatro proyectos adjudicados; otros cuatro en los Núcleos en Ciencias Sociales; y en tres Anillos en Ciencias Naturales y Tecnología. Todos ellos son clave para fomentar la investigación en Chile y generar las bases de conocimiento en temas específicos.

photo_camera "Estas nuevas adjudicaciones de proyectos de investigación reflejan el compromiso de nuestros académicos y académicas de hacer una contribución clave a la ciencia y al desarrollo de nuestro país", expresa el rector Ignacio Sánchez respecto de los resultados obtenidos por la UC en las convocatorias 2021 de Núcleos en Ciencias Naturales y Exactas, y Ciencias Sociales; y Anillos en Ciencias Naturales y Tecnología. (Crédito fotografía: Karina Fuenzalida)
Impulsar la formación de proyectos asociativos que fomenten la investigación chilena y la generación de nuevo conocimiento, así como la formación de investigadores, la creación de redes internacionales y la divulgación hacia la sociedad, es el objetivo de los concursos impulsados por la Agencia Nacional de Investigación y Desarrollo (ANID), que fueron adjudicados recientemente.
Se trata de los Núcleos Milenio en Ciencias Naturales y Exactas, y en Ciencias Naturales; y Anillos en Ciencia y Tecnología 2021. Todos estos son concursos altamente competitivos, por lo que es un gran logro para nuestra universidad estar participando en un número importante de propuestas adjudicadas.
“Estas nuevas adjudicaciones de proyectos de investigación reflejan el compromiso de nuestros académicos y académicas de hacer una contribución clave a la ciencia y al desarrollo de nuestro país, poniéndola a disposición de las necesidades de las personas, y respondiendo a problemas que nos afectan como sociedad, desde temas de salud, alimentación, astronomía y sustentabilidad, hasta educación, trabajo y movilidad, entre otros”, afirma el rector Ignacio Sánchez.
“Estamos muy contentos, primero por los muy buenos resultados que ha tenido la UC en estas adjudicaciones y segundo, porque estos proyectos asociativos realizan un rol crucial en la generación de nuevo conocimiento, tanto a nivel nacional como global, y en la formación de las nuevas generaciones de investigadores e investigadoras, y el desarrollo de una base para la creación de nuevos centros de excelencia”, agrega el vicerrector de Investigación Pedro Bouchon.
Como añade la directora de Investigación María Elena Boisier: “Estos resultados, que posicionan a la UC como la universidad con el mayor número de proyectos adjudicados, son reflejo de la dedicación de las profesoras, profesores y equipos profesionales que han realizado una gran labor para sacar adelante estas propuestas, las que no solo aportarán a la investigación, sino que también pondrán el nuevo conocimiento al servicio de las comunidades, acercando la ciencia a las personas”.
Núcleos Milenio en Ciencias Naturales y Exactas

Los Núcleos Milenio son financiados por la Iniciativa Científica Milenio, programa de la ANID, por un periodo de tres años, con la posibilidad de renovar por la misma cantidad de tiempo. En el concurso 2021, se presentaron un total de 95 postulaciones a nivel nacional. De ellas, solo 18 pasaron a etapa de entrevistas, siendo finalmente adjudicados ocho proyectos en total. La UC participa en cuatro de estas propuestas, siendo tres nuevas y una renovación.
Se debe destacar que en total, la UC participó en 31 proyectos postulados admisibles: 28 propuestas nuevas y 3 de renovación; siendo la UC la institución albergante principal en 13 de ellas.
1. Núcleo Milenio para la Evolución Reconstruida del medio IntereStelar - ERIS: Como explica la profesora del Instituto de Astrofísica Patricia Tissera, directora alterna, el núcleo busca aplicar “uno de los principios básicos de la Teoría de Evolución de Darwin -descendencia con modificación- a la evolución cósmica. Se propone reconstruir la evolución de galaxias construyendo e interpretando árboles filogenéticos -herramienta que muestra las relaciones evolutivas entre varias especies u otras entidades que se cree que tienen una ascendencia común- apropiados para datos astronómicos. En nuestro grupo, simularemos la evolución de galaxias, a partir de la cual podemos reconstruir la historia de ensamblaje, y la evolución química del medio interestelar y las poblaciones estelares. Estas simulaciones permitirán estudiar la performance de los nuevos algoritmos de árboles filogenéticos, proveyéndoles el contexto y la interpretación física dentro de una narrativa cosmológica”.
2. Núcleo Milenio de Agronomía Marina de Holobiontes Macroalgales - MASH: Como cuenta el director alterno, el profesor de la Facultad de Ciencias Biológicas Sylvain Faugeron, el principal aporte que busca entregar este proyecto es impulsar el cultivo de algas en Chile. El país es el primer productor no asiático de algas y el sexto a nivel mundial (por delante de Japón, por ejemplo). Pero esta esta producción se sustenta esencialmente en extracción de praderas naturales y cultivos artesanales. “Pensamos que Chile está en condiciones de consolidar su liderazgo en producción de algas, lo que requiere profundizar conocimientos biológicos con un fuerte enfoque en aplicaciones en la mejora de la productividad y la resiliencia de las praderas cultivadas”, afirma. Un desafío importante, es que la investigación requiere de un vínculo fuerte entre académicos y productores. El cultivo de algas en Chile está actualmente dominado por familias de pescadores artesanales que mantienen la actividad como complemento a la pesca. “El objetivo es doble: aprender y entender los requerimientos biológicos de las algas en condiciones de cultivo, determinadas por el lugar y las prácticas; y aportar a los productores conocimiento esencial y soluciones a los problemas de productividad, pestes y patógenos, y de resiliencia frente a la dinámica del océano costero”, finaliza.
3. Núcleo Milenio sobre el Límite de la Vida Patagónica: Restricciones Ambientales en Genética y Ecofisiología - Lili: Este proyecto, que es liderado por la Universidad Austral, tendrá a la profesora de Agronomía e Ingeniería Forestal UC Juliana Vianna como investigadora principal. Su objetivo es comprender cómo los bosques de Nothofagus del sur de América del Sur mantienen un ecosistema de crecimiento estacional, así como caracterizar su resiliencia a los cambios ambientales. El proyecto busca impulsar iniciativas socioeconómicas regionales sostenibles, como el desarrollo de posibilidades para la industria local, ya que los bosques patagónicos contienen la fuente de diversidad mundial de levaduras nativas, con enorme potencial para la elaboración de bebidas fermentadas (como la cerveza); y el asesoramiento a los responsables en la toma de decisiones en conservación.
4. Núcleo Milenio en Procesos Catalíticos hacia la Química Sustentable: Su director, el profesor de la Escuela de Ingeniería Néstor Escalona, explica que la renovación de este núcleo “significa un respaldo en nuestra investigación para buscar alternativas sustentables para la industria química”. La disminución de las reservas de petróleo, el aumento del precio y la demanda de la energía, así como la manifiesta amenaza de los gases de efecto invernadero, han motivado a la sociedad a buscar nuevos recursos para reemplazar los combustibles fósiles. La biomasa es la única fuente para la producción de combustibles y productos químicos que puede reemplazar el petróleo. De ahí que el principal aporte de este proyecto, como cuenta el investigador, “es estudiar diferentes catalizadores para la producción de hidrógeno y productos químicos de alto valor agregado a partir de derivados de la biomasa”.
Núcleos Milenio en Ciencias Sociales

En total, postularon 71 propuestas, de las cuales veinte pasaron a la etapa de entrevistas a nivel nacional. Finalmente solo diez fueron adjudicadas. De estas, la UC participa en cuatro -tres nuevas y una renovación-.
1. Núcleo Milenio para el Estudio del Desarrollo de las Habilidades Matemáticas Tempranas - MEMAT: Su objetivo es comprender cómo las experiencias matemáticas de los niños y niñas -en el hogar, educación temprana y en la escuela- contribuyen a generar oportunidades equitativas de aprendizaje, e identificar los mecanismos que aseguran trayectorias matemáticas exitosas en el futuro. El desarrollo de las habilidades matemáticas tempranas es crucial, porque se asocia al rendimiento escolar y a las trayectorias matemáticas futuras de los estudiantes; sin embargo, aún persisten brechas socioeconómicas y de género importantes. “El núcleo investigará los mecanismos individuales y contextuales que promueven las habilidades matemáticas tempranas y las trayectorias exitosas de aprendizaje matemático, enfocándose en las inequidades de género y de nivel socioeconómico”, explica su directora, la profesora de la Facultad de Educación María Inés Susperreguy, quien también destaca la interdisciplina y la innovación, la formación de alianzas internacionales y el aporte a las políticas públicas en la materia que hará este proyecto.
2. Núcleo Milenio sobre la Evolución del Trabajo: Como cuenta su directora, la profesora del Instituto de Economía Jeanne Lafortune, este núcleo permitirá profundizar cómo ha sido la evolución del trabajo y cómo lo hará en el futuro. “Primero, queremos entender el impacto que tiene el cambio tecnológico en el mundo del trabajo. Hay mucha evidencia para países ricos, pero mucho menos en países emergentes como en América Latina y particularmente, Chile. También queremos estudiar cómo cambió la organización del mundo del trabajo, pasando a un tipo de relación laboral más flexible, pero también potencialmente más precaria. La investigación se enfoca en estudiar el tema de manera multidisciplinaria, incluyendo especialistas en economía, psicología, sociología e historia, y con metodologías muy diversas”.
3. Núcleo Milenio sobre Movilidad Intergeneracional: del Modelamiento a la Política Pública: La pregunta que intenta responder este núcleo es: ¿Cuántas generaciones le cuesta a una familia poder salir de la pobreza? Como explica su director, el profesor de la Facultad de Matemáticas Ernesto San Martín, la interrogante contiene una serie de presupuestos y dificultades: “¿Qué se quiere decir con "familia"? ¿Debemos medir la movilidad solo usando indicadores como salario? ¿Qué ocurre si intentamos entender la movilidad usando niveles educacionales? Y, ¿qué ocurre cuando focalizamos nuestra atención sobre la movilidad de las mujeres? Pero hay más: ¿cómo sabemos si estamos midiendo bien los salarios, los ingresos, los niveles educacionales?... Nuestro aporte es abrirnos a la complejidad de estas y otras preguntas, y responderlas de la manera menos incierta posible. Por ello tenemos un equipo interdisciplinario: estadísticos, econometras, psicólogos y expertos en políticas públicas, para poder combinar teorías sustantivas en relación a la movilidad social, con datos administrativos chilenos, para poder extraer conclusiones y recomendaciones”. En este equipo también participa, como directora alterna, la profesora del Instituto de Economía Claudia Martínez.
4. Núcleo Milenio Experiencia Estudiantil en Educación Superior en Chile: Expectativas y Realidades - NMEdSup: Este proyecto analiza las expectativas y experiencias de los estudiantes sobre la Educación Superior; incluyendo la transición desde la enseñanza media y al mundo del trabajo; considera también una exploración profunda de las políticas asociadas. Como afirma su director, el profesor de la Facultad de Educación Carlos González, la renovación de este núcleo “es un logro muy importante, que consolida la línea de trabajo que hemos venido realizando, sobre todo en el contexto actual de enormes desafíos y profundos cambios en el sistema. Estamos muy orgullosos y orgullosas, además, de haber sido evaluados tan positivamente por los pares internacionales, obteniendo el primer lugar del ranking, empatados con un núcleo nuevo. Creemos que es una tremenda oportunidad para seguir aportando a los debates globales sobre Educación Superior y a la práctica de las instituciones del área en nuestro país". Como directora alterna participa la también profesora de la Facultad de Educación, Verónica Santelices.
Anillos en Ciencia y Tecnología

Los Anillos, impulsados por la ANID, buscan impulsar el desarrollo de áreas temáticas específicas, y tiene como objetivo fortalecer y consolidar grupos de investigadores estructurados en áreas de investigación avanzada a nivel nacional. Su labor comprende actividades de investigación; formación de estudiantes, principalmente de postgrado; integración con redes y centros de investigación, nacionales y extranjeros; y divulgación y transferencia de conocimiento hacia la sociedad.
En el concurso 2021, se presentaron a nivel nacional un total de 102 postulaciones, de las cuales 98 resultaron admisibles. De estas, fueron adjudicadas 31. En total, la UC participó en 28 proyectos postulados: 15 como institución principal y 13 como asociada.
Los tres proyectos adjudicados en que la UC es la institución principal son los siguientes:
1. Sistemas ciberfísicos para la atención médica personalizada: un enfoque basado en datos para mejorar el manejo de la diabetes y la hipertensión. Debido a cambios demográficos, estilos de vida e incidencia de enfermedades, los sistemas de salud están enfrentando numerosos desafíos, entre ellos, una creciente demanda de especialistas, el envejecimiento de la población, un aumento de enfermedades crónicas, y la dificultad de garantizar acceso a la población a un sistema sustentable y de calidad. De ahí que el uso de sistemas tecnológicos para apoyar a especialistas de la salud y pacientes en la toma de decisiones compartida, es una alternativa atractiva para mejorarla eficiencia y lograr generar una experiencia personalizada. Es por esto que este anillo busca desarrollar sistemas tecnológicos que se hagan cargo de problemas abiertos en el área del manejo de enfermedades crónicas, con particular foco en diabetes e hipertensión. Este desafío será liderado por la profesora del Instituto de Ingeniería Biológica y Médica María Rodríguez, como directora, y la profesora de la Escuela de Ingeniería Valeria Herskovic, como directora alterna.
2. Nuevos conocimientos sobre el control de la función vascular dependiente del endotelio mediante la aparición de canales de Na + dependientes del voltaje en la señalización de las células endoteliales. Como explican los profesores de la Facultad de Ciencias Biológicas Xavier Figueroa, director de este anillo, y Nelson Barrera, director alterno, junto al profesor de la Facultad de Química y de Farmacia Eduardo Schott: “Es un importante honor y reconocimiento haber obtenido la adjudicación de este proyecto. Su desarrollo representa una excelente oportunidad para consolidar una interacción interdisciplinaria que nos permitirá profundizar en un aspecto muy novedoso del sistema cardiovascular. Este estudio será un importante avance en el conocimiento de la fisiología y patofisiología del sistema circulatorio, pero también aportará nuevas herramientas farmacológicas que podrían permitir el desarrollo de estrategias terapéuticas alternativas para el tratamiento de enfermedades como la hipertensión, la inflamación o condiciones relacionadas con un crecimiento alterado de los vasos”.
3. Regulación neuroendocrina de la ingesta de alimentos y el gasto energético: una visión integrada de la obesidad y la lipodistrofia: “La obesidad es una epidemia mundial, y debemos entender mucho mejor cómo funciona el complejo proceso del apetito y metabolismo para ayudar a disminuir esta enfermedad”, afirma el director de este anillo, el profesor de la Escuela de Medicina René Baudrand, y agrega: “Nos llamó la atención que la mayoría de las hormonas reguladoras del apetito se han estudiado en forma separada y no en forma integrada como realmente funcionan. Es por eso que diseñamos estudios más interactivos donde se puede evaluar cómo cambian las otras hormonas al suplementar o bloquear una tercera”. En concreto estudiarán el cortisol, producido en la glándula suprarrenal; la leptina, en el tejido graso; y GLP-1, en el intestino. “Somos un equipo multidisciplinario de médicos y biólogos, del área clínica y más básica, algunos dedicados a temas endocrinos, otros más fisiológicos y otros del área nutricional. El complemento hasta ahora ha sido muy beneficioso”, finaliza. En el equipo participa como director alterno el también profesor de la Escuela de Medicina Claudio Pérez.





